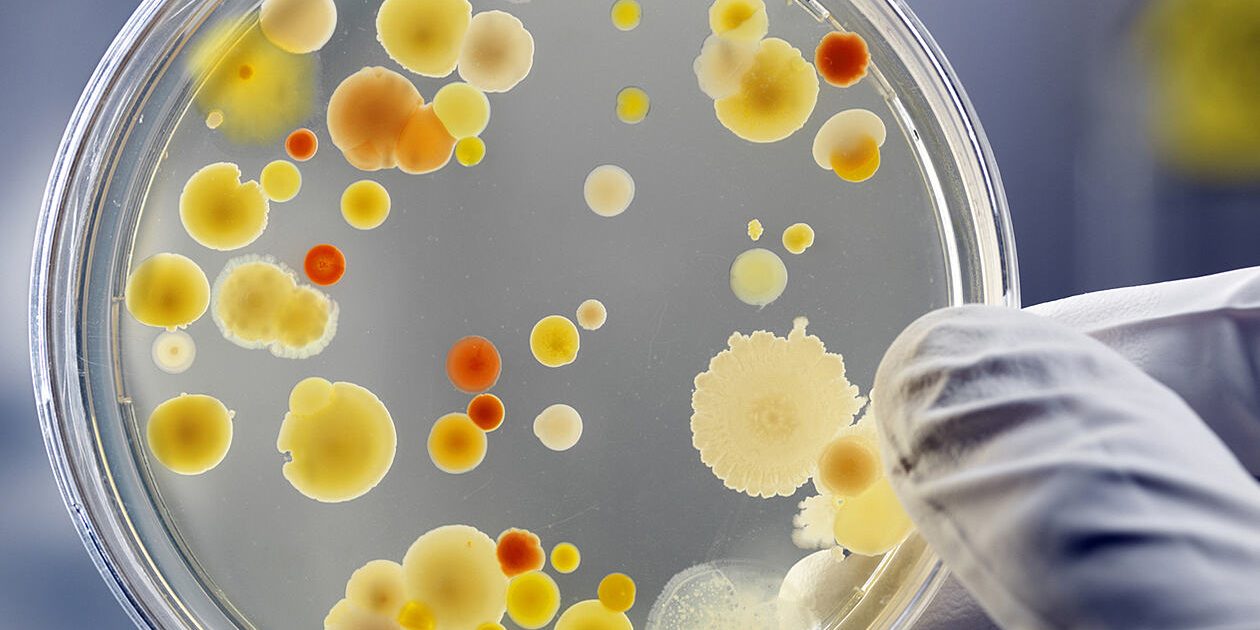
microbiology

بخش میکروبیولوژی در آزمایشگاه چکاپ، یکی از مهمترین و پویاترین بخشهای آزمایشگاهی است که به بررسی و تشخیص انواع میکروارگانیسمها مانند باکتریها، ویروسها، قارچها و انگلها میپردازد. این بخش با بهرهگیری از تجهیزات پیشرفته و روشهای آزمایشگاهی دقیق، نقش حیاتی در تشخیص بیماریهای عفونی و ارائه راهنماییهای مهم برای درمان مناسب دارد.
در بخش میکروبیولوژی، ما از طیف گستردهای از تکنیکها و روشها استفاده میکنیم، از جمله:
- کشت میکروبی: روشی برای رشد و شناسایی میکروارگانیسمها در محیطهای کشت مخصوص.
- میکروسکوپی: استفاده از میکروسکوپ برای مشاهده مستقیم میکروارگانیسمها.
- آزمایشهای بیوشیمیایی: برای تعیین ویژگیهای متابولیکی و شناسایی میکروبها.
- تکنیکهای مولکولی: مانند PCR، برای شناسایی سریع و دقیق میکروارگانیسمها.
این بخش همچنین در تعیین حساسیت یا مقاومت میکروارگانیسمها به آنتیبیوتیکها و دیگر داروهای ضدمیکروبی نقش مهمی دارد. به این ترتیب، میتوانیم اطلاعات ارزشمندی را در اختیار پزشکان قرار دهیم تا بتوانند درمانی موثر و هدفمند را برای بیماران خود تجویز کنند.
کادر متخصص بخش میکروبیولوژی آزمایشگاه چکاپ با تعهد به کیفیت و دقت، متعهد به ارائه نتایج قابل اعتماد و سریع هستند تا به بهترین شکل ممکن به نیازهای تشخیصی و درمانی بیماران پاسخ دهند.